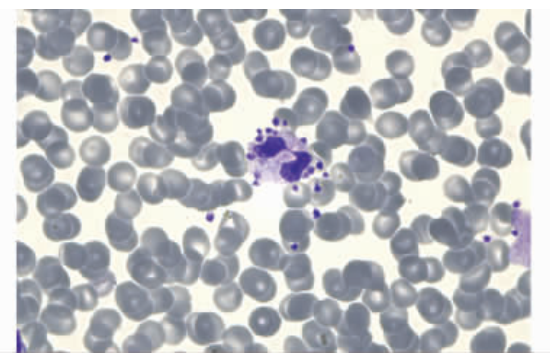
嗜酸性粒细胞增多的 10 大原因,最后一种很容易误诊! 嗜酸性粒细胞增多的 10 大原因,最后一种很容易误诊!

任何原因引起外周血嗜酸粒细胞绝对计数 > 0.5×109/L,即为嗜酸性粒细胞增多症;根据外周血嗜酸性粒细胞绝对值计数,分为以下几种程度:

其常见原因如下:
正常人嗜酸性粒细胞白天较低,夜间较高。上午波动较大,下午比较恒定。
可发生轻至中度的嗜酸性粒细胞增多,常见于支气管哮喘、荨麻疹、血管神经性水肿、血清病、花粉症等。
一些药物反应可导致外周血嗜酸性粒细胞增多,如抗疟疾药、β- 内酰胺类、环丙沙星、糖肽类抗生素、磺胺类药物、抗结核药物、心血管药物、抗惊厥药等。
药物引起的嗜酸性粒细胞增多临床上比较少见且大多不严重,但是临床用药中仍需要注意。
1)寄生虫感染:特别是当其侵犯肠道外组织时,嗜酸性粒细胞增多更显著。引起嗜酸性粒细胞增多的寄生虫感染主要有:血吸虫、肺吸虫、肝吸虫、蛲虫 蛔虫、钩虫、疟原虫、弓形虫等。
2)有些真菌也可引起嗜酸性粒细胞增多,如曲霉菌。
3)逆转录病毒感染有时可伴有嗜酸性粒细胞增多,如人类嗜 T 细胞病毒 HTLV-II 和 HTLV-I 感染、HIV 感染。
4)结核,特别是淋巴结干酪样结核也可使嗜酸性粒细胞增多。
1)各种恶性肿瘤患者约 0.5% 伴有嗜酸性粒细胞增多,如支气管肺癌、宫颈癌、胃癌、直肠癌等;
2)某些血液病,如慢性粒细胞白血病、多发性骨髓瘤、嗜酸性粒细胞白血病等可见嗜酸性粒细胞增多;
3)霍奇金病也可有外周血嗜酸细胞增多,其他淋巴瘤则少见;
4)嗜酸性粒细胞肉芽肿、类癌亦可使嗜酸性粒细胞增多。
嗜酸性粒细胞增多常见于:系统性红斑狼疮、类风湿关节炎、皮肌炎、血管炎、结节性多动脉炎、干燥综合征等疾病,可反映疾病的活动度。
正常情况下,体内的糖皮质激素能抑制嗜酸性粒细胞,当肾上腺皮质功能减退症时可见嗜酸性粒细胞增多。此外,单一性腺垂体功能不全也可见嗜酸性粒细胞增多。
嗜酸粒细胞性肺炎又嗜酸粒细胞性肺浸润,是一组病因尚不明确、发病机制与变态反应有关的疾病。
临床上可分为四型:单纯型嗜酸性粒细胞肺浸润或 Loffler 综合征、慢性嗜酸性肺炎或迁延型嗜酸性粒细胞肺浸润、热带型肺嗜酸粒细胞浸润症、哮喘型嗜酸粒细胞肺浸润症或过敏性支气管曲菌病。四个类型有着共同的呼吸道症状,包括咳嗽、气短、胸闷和哮喘等。

原发性嗜酸性粒细胞增多症又称高嗜酸粒细胞综合征(HES) ,1975 年 Chusid 等提出了 IHES 的具体诊断标准,并沿用至今:① 嗜酸粒细胞绝对数 > 1.5X109/L,持续 6 个月或以上;② 未发现引起嗜酸粒细胞增多的常见原因;③ 有多系统及多脏器受累的证据。HES 的分类主要有:
(1)克隆性嗜酸性粒细胞增多综合征:即存在明确的干细胞或髓系肿瘤作为基础疾病,致嗜酸性粒细胞克隆性增生。
(2)特发性高嗜酸粒细胞综合征(IHES):
IHES 是一组原因不明的嗜酸性粒细胞增多性疾病,嗜酸粒细胞心内膜炎也属于此组疾病。IHES 没有任何克隆性细胞遗传学异常。
1)严重感染时,中性粒细胞出现大量中毒颗粒,在结构上增加了其复杂性,SSC 信号值增大出现右移,导致 WDF 通道散点图异常,造成嗜酸性粒细胞假性增高。


2)当患者存在疟原虫感染、白血病尤其是急性感染时,某些全自动血细胞分析仪 WDF 通道可出现散点图异常,仪器对中性粒细胞和嗜酸性粒细胞的分辨能力下降,易造成嗜酸性粒细胞的假性增高。
3)存在血小板卫星现象:由于 EDTA-K2 诱导体液产生冷抗血小板抗体,这种自身抗体作用在血小板膜上同时又可以与中性粒细胞膜上 Fc 受体相结合出现卫星现象。由于围绕在中性粒细胞周围的血小板颗粒增加了中性粒细胞结构的复杂性,在通过 WDF 通道时 SSC 信号值增大右移,使中性粒细胞出现在嗜酸性粒细胞区域,导致嗜酸性粒细胞假性增高。
4)由于标本放置时间过短,导致检测结果嗜酸性粒细胞假性增高。采集血液标本于 EDTA-K2 抗凝管中,血小板会发生可逆性聚集情况,此时进行血常规分析造成血小板计数假性减低而白细胞计数假性升高。
[1] 郎奕。药物引起的嗜酸性粒细胞增多 [J]. 天津药学,2003, 15 (1):4.
[2] 李承新。嗜酸性粒细胞增多性皮肤病的鉴别诊断 [J]. 皮肤病与性病,2013 (6):328-330.
[3] 张春玲。嗜酸粒细胞性肺炎 [J]. 中国临床医生,2004,32 (2):6-7. .
[4] 陆珍芳。不同原因致嗜酸性粒细胞增多综合征并肺动脉栓塞 3 例并文献复习 [D]. 广西:广西医科大学,2017.
[5] 边春红,郭胜香,徐丽娟等.5 例嗜酸性粒细胞假性增高原因分析 [J]. 标记免疫分析与临床,2021,28 (05):891-895.
[6] 沈莉菁,韩洁英,陈芳源。原发性嗜酸粒细胞增多症的诊疗进展 [J]. 临床血液学杂志,2008, 21 (3):285-288.
[6] 肖中平。嗜酸性粒细胞增多症的病因调查研究 [J]. 中国卫生产业,2016, 13 (30):3.

